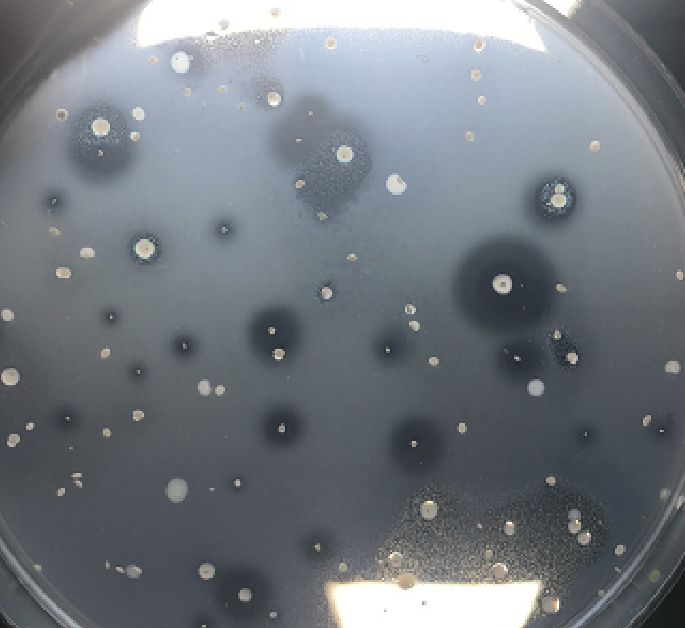
无良商家用芽孢杆菌冒充蛭弧菌，价格相差巨大！转起，踢爆*局骗**

随着蛭弧菌产品的热销,市场上却出现了一些打着蛭弧菌的名义,假冒蛭弧菌的产品。今天这篇文章教大家辨别真假“蛭弧菌”,踢爆无良厂家*局骗**。
蛭弧菌是自然界广泛存在的益生菌,在当前全面禁止抗生素使用的大环境下,蛭弧菌是预防水产动物细菌性病害暴发的最佳选择。随着蛭弧菌产品的热销,市场上却出现了一些打着蛭弧菌的名义,假冒蛭弧菌的产品。这类产品经16S rDNA菌种鉴定后发现,其中绝大部分是芽孢杆菌。在外塘使用方面,用这些芽孢杆菌假冒的“蛭弧菌”来控制弧菌等有害细菌,基本没有任何效果,还容易造成缺氧等危害。
市场上的芽孢杆菌价格很低,与真正的蛭弧菌相比,有着十几倍的差价,正是在暴利的驱使下,不良企业通过利用芽孢杆菌会产生溶菌蛋白酶的特性,以蛋白酶形成的抑菌圈,混淆为蛭弧菌的噬菌斑,来达到欺骗客户,获取暴利的目的。
此类产品在实验室采用双层平板进行蛭弧菌数量检测时,检测平板上全部会出现中间有白点的“抑菌斑”,与真正的噬菌斑有明显的不同,对于不经常检测蛭弧菌的专业技术人员而言,有很强的迷惑性及欺骗性。

图1“噬菌斑”中间无白点,真!
图2 噬菌斑中间有白点,假!
鉴别真假蛭弧菌,可以通过以下几个途径进行:
1、最科学严谨的方法是细菌DNA身份验证:16S rDNA 菌种鉴定
我们都知道每种细菌都有特异的DNA序列,通过用蛭弧菌的特异性引物,进行16S rDNA细菌种类鉴定,观察胶图条带情况即可准确辨别蛭弧菌真伪,这是最科学和严谨的。我们过去做菌种鉴定耗时长,价格高,大家懒于去做,现在2天就可以搞定,单品费用也就100-200元。根据图3中的条带可以判断:样品H2和H3呈强阳性,H1和CK2呈弱阳性,均为蛭弧菌;CK为阴性,非蛭弧菌。

图3 PCR扩增结果鉴定胶图
2、养殖现场使用效果的验证:除去养殖现场各种因素的干扰,真正的蛭弧菌在大塘的使用的有效率可达50%以上且效果非常明显,而使用芽孢杆菌冒充的“蛭弧菌”,在外塘基本没有效果。
3、供货企业资质的认证:优质动保原料的采购,是企业质量稳定的第一步。正规原料企业生产蛭弧菌,必须具备专业的微生物实验室、液体发酵罐、真空冷冻干燥机等关键设备,没有这些设备,蛭弧菌生产也就无从谈起。对于原料采购商来讲,现场考察是必要的。
4、对于号称进口蛭弧菌的原料商,动保企业可以向对方索要进口凭证。据我们所了解的信息,目前海关并没有任何蛭弧菌的进口许可及进口记录。